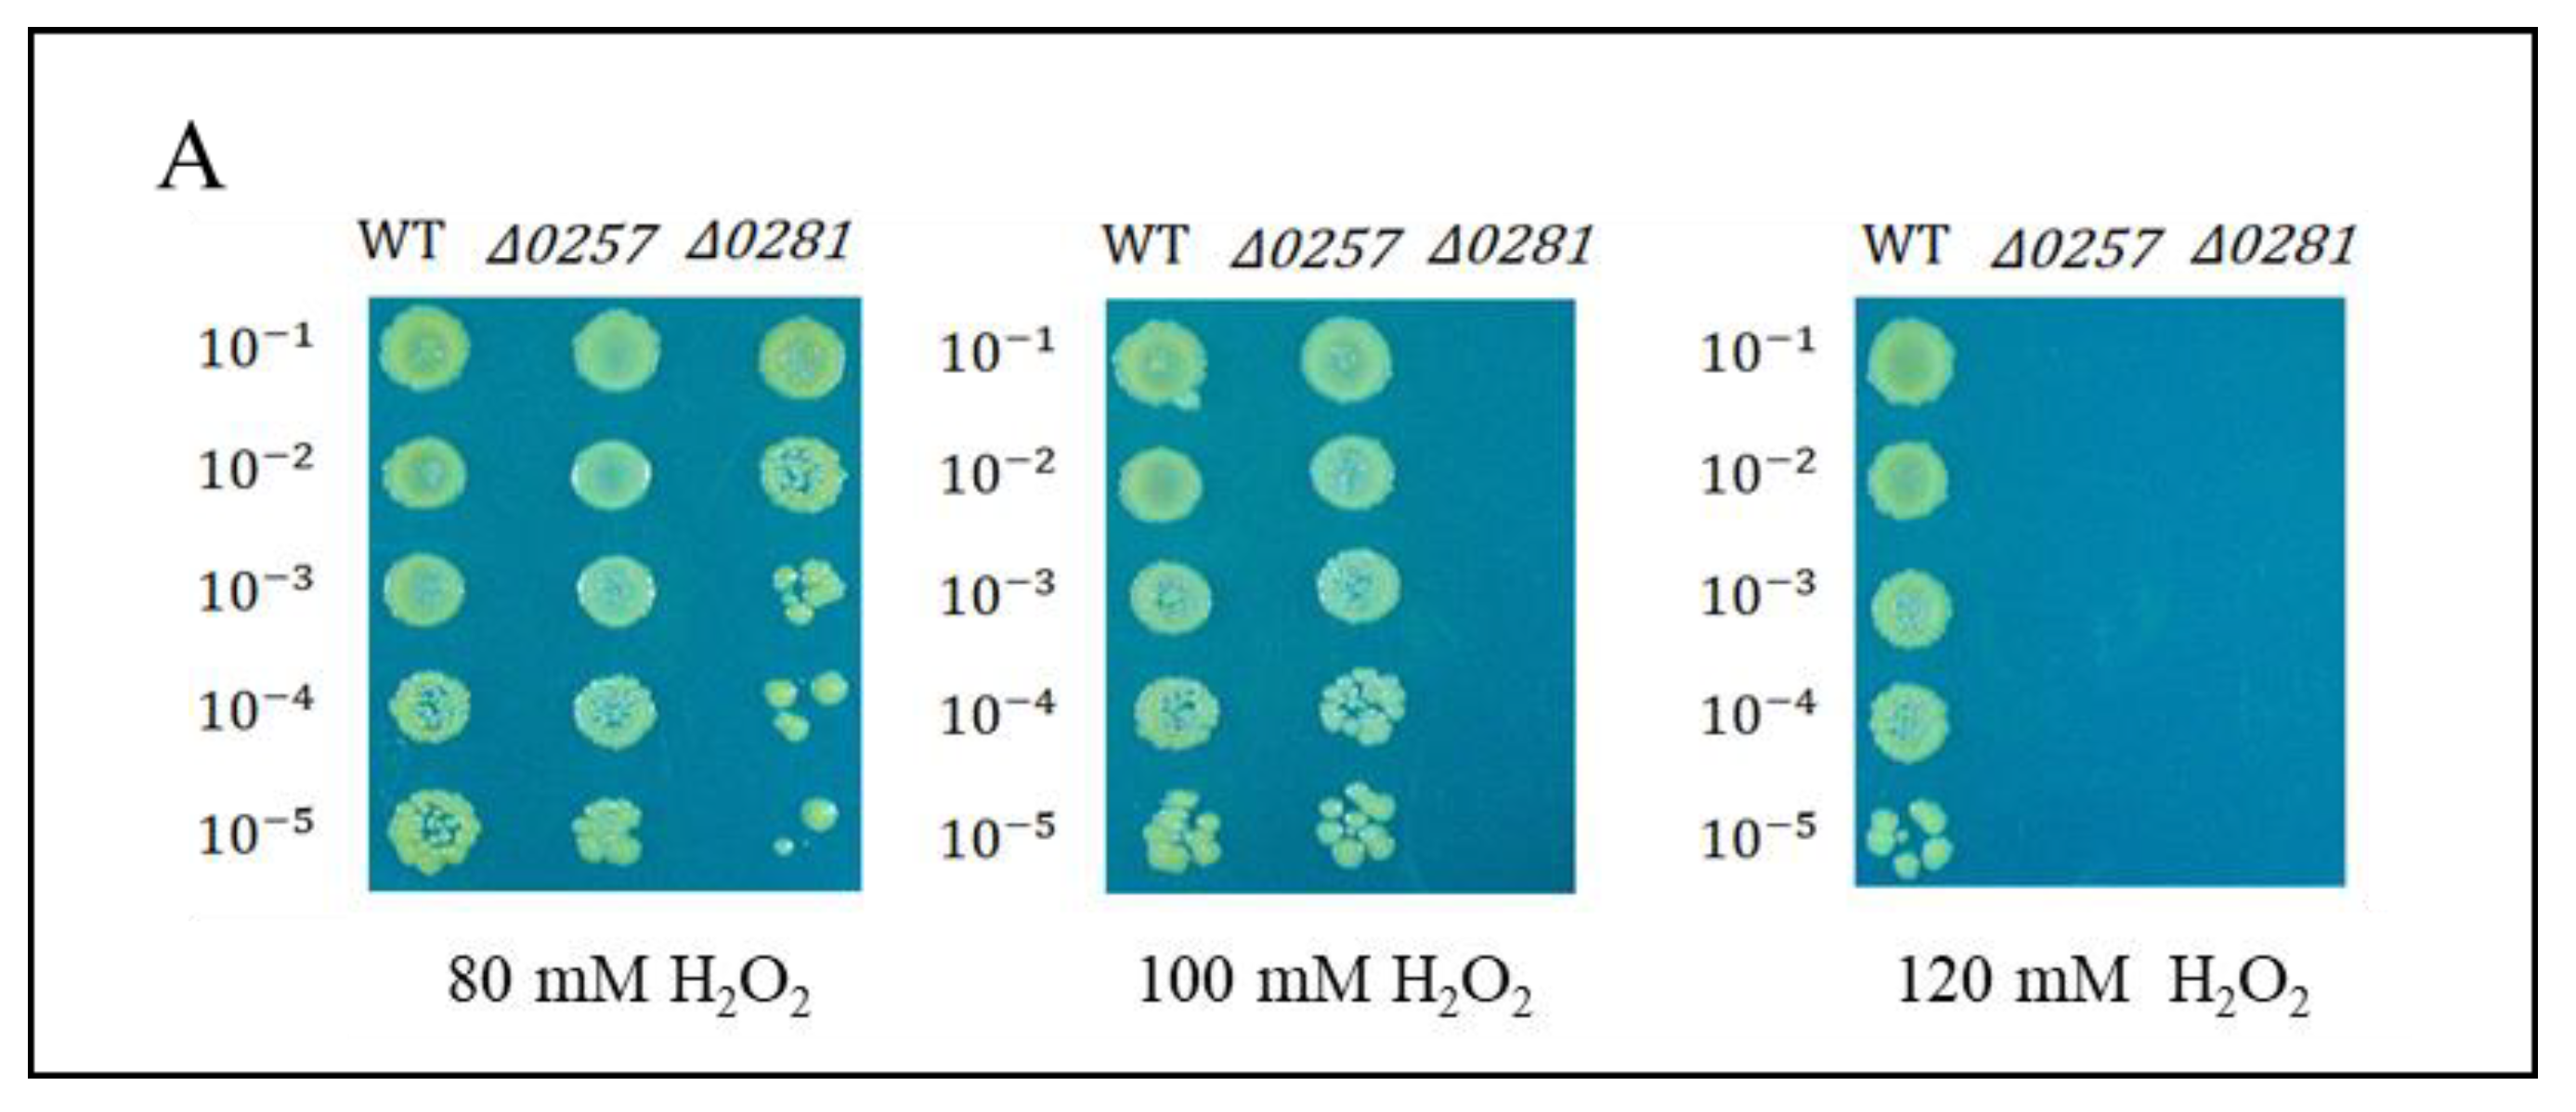
Ijms 24 00469 g005a Ijms 24 00469 g005a

Complementary Roles of Two DNA Protection Proteins from Deinococcus geothermalis
Abstract
1. Introduction
2. Results
2.1. Characteristics of Amino Acid Sequences of a Putative Dps Dgeo_0257 and DgDps1
2.2. Purification and Conformation of Dgeo_0257 and DgDps1 Proteins
2.3. DNA-Binding and Protection Properties of Dgeo_0257 and DgDps1 Proteins
2.4. Effect of Metal Ion Sensing on the DNA-Binding Activity of a Putative Dps Dgeo_0257 and DgDps1
2.5. Physiological Properties of Dps-Gene-Disrupted Mutants
2.6. Expression Levels of Dgeo_0257 and DgDps1 Genes through Antiparallel Influence in a Growth-Phase-Dependent Manner
3. Discussion
4. Materials and Methods
4.1. Bacterial Strains and Culture Condition
4.2. Construction of an Expression Vector for Dgeo_Dps Genes
4.3. Purification of the Putative Dps Protein (Dgeo_0257) and DgDps1 (Dgeo_0281)
4.4. Determination of Protein Conformation by Gel Filtration
4.5. Electrophoretic Mobility Shift Assay (EMSA)
4.6. qRT-PCR Analysis of Wild-Type and Δdgeo_0257 and Δdgeo_0281 Mutant Strains at Different Growth Phases
5. Conclusions
Supplementary Materials
Author Contributions
Funding
Institutional Review Board Statement
Informed Consent Statement
Data Availability Statement
Acknowledgments
Conflicts of Interest
References
- Ferreira, A.C.; Nobre, M.F.; Rainey, F.A.; Silva, M.T.; Wait, R.; Burghardt, J.; Chung, A.P.; da Costa, M.S. Deinococcus geothermalis sp. nov. and Deinococcus murrayi sp. nov., two extremely radiation-resistant and slightly thermophilic species from hot spring. Int. J. Syst. Bacteriol. 1997, 47, 939–947. [Google Scholar] [CrossRef] [PubMed]
- Makarova, K.S.; Omelchenko, M.V.; Gaidamakova, E.K.; Matrosova, V.Y.; Vasilenko, A.; Zhai, M.; Lapidus, A.; Copeland, A.; Kim, E.; Land, M.; et al. Deinococcus geothermalis: The pool of extreme radiation resistance genes shrinks. PLoS ONE 2007, 2, e955. [Google Scholar] [CrossRef] [PubMed]
- Slade, D.; Radman, M. Oxidative stress resistance in Deinococcus radiodurans. Microbiol. Mol. Biol. Rev. 2011, 75, 133–191. [Google Scholar] [CrossRef] [PubMed]
- Brim, H.; Venkateswaran, A.; Kostandarithes, H.M.; Fredrickson, J.K.; Daly, M.J. Engineering Deinococcus geothermalis for bioremediation of high-temperature radioactive waste environments. Appl. Environ. Microbiol. 2003, 69, 4574–4582. [Google Scholar] [CrossRef] [PubMed]
- Daly, M.J.; Gaidamakova, E.K.; Matrosova, V.Y.; Vasilenko, A.; Zhai, M.; Venkateswaran, A.; Hess, M.; Omelchenko, M.V.; Kostandarithes, H.M.; Makarova, K.S.; et al. Accumulation of Mn(II) in Deinococcus radiodurans facilitates gamma-radiation resistance. Science 2004, 306, 1025–1028. [Google Scholar] [CrossRef] [PubMed]
- Daly, M.J. A new perspective on radiation resistance based on Deinococcus radiodurans. Nat. Rev. Microbiol. 2009, 7, 237. [Google Scholar] [CrossRef]
- Rainey, F.A.; Ray, K.; Ferreira, M.; Gatz, B.Z.; Nobre, M.F.; Bagaley, D.; Rash, B.A.; Park, M.J.; Earl, A.M.; Shank, N.C.; et al. Extensive diversity of ionizing-radiation-resistant bacteria recovered from Sonoran Desert soil and description of nine new species of the genus Deinococcus obtained from a single soil sample. Appl. Environ. Microbiol. 2005, 71, 5225–5235. [Google Scholar] [CrossRef]
- Gerber, E.; Bernard, R.; Castang, S.; Chabot, N.; Coze, F.; Dreux-Zigha, A.; Hauser, E.; Hivin, P.; Joseph, P.; Lazarelli, C.; et al. Deinococcus as new chassis for industrial biotechnology: Biology, physiology and tools. J. Appl. Microbiol. 2015, 119, 1–10. [Google Scholar] [CrossRef]
- Ranawat, P.; Rawat, S. Stress response physiology of thermophiles. Arch. Microbiol. 2017, 199, 391–414. [Google Scholar] [CrossRef]
- Chiancone, E.; Ceci, P. The multifaceted capacity of Dps proteins to combat bacterial stress conditions: Detoxification of iron and hydrogen peroxide and DNA binding. Biochim. Biophys. Acta 2010, 1800, 798–805. [Google Scholar] [CrossRef]
- Andrews, S.C. The Ferritin-like superfamily: Evolution of the biological iron storeman from a rubrerythrin-like ancestor. Bioch. Biophys. Acta 2010, 1800, 691–705. [Google Scholar] [CrossRef] [PubMed]
- Zeth, K. Dps biomineralizing proteins: Multifunctional architects of nature. Biochem. J. 2012, 445, 297–311. [Google Scholar] [CrossRef] [PubMed]
- Haikarainen, T.; Papageorgiou, A.C. Dps-like proteins: Structural and functional insights into a versatile protein family. Cell Mol. Life Sci. 2010, 67, 341–351. [Google Scholar] [CrossRef] [PubMed]
- Almirón, M.; Link, A.J.; Furlong, D.; Kolter, R. A novel DNA binding protein with regulatory and protective roles in starved Escherichia coli. Genes Dev. 1992, 6, 2646–2654. [Google Scholar] [CrossRef] [PubMed]
- Calhoun, L.N.; Kwon, Y.M. Structure, function and regulation of the DNA-binding protein Dps and its role in acid and oxidative stress resistance in Escherichia coli: A review. J. Appl. Microbiol. 2010, 110, 375–386. [Google Scholar] [CrossRef]
- Ushijima, Y.; Yoshida, O.; Villanueva, M.J.A.; Ohniwa, R.L.; Morikawa, K. Nucleoid clumping is dispensable for the Dps-dependent hydrogen peroxide resistance in Staphylococcus aureus. Microbiology 2016, 162, 1822–1828. [Google Scholar] [CrossRef]
- Thieme, D.; Grass, G. The Dps protein of Escherichia coli is involved in copper homeostasis. Microbiol. Res. 2010, 165, 108–115. [Google Scholar] [CrossRef]
- Fredrickson, J.K.; Kostandarithes, H.M.; Plymale, A.E.; Daly, M.J. Reduction of Fe(III), Cr(VI), U(VI), and Tc(VII) by Deinococcus radiodurans R1. Appl. Environ. Microbiol. 2000, 66, 2006–2011. [Google Scholar] [CrossRef]
- Tonello, F.; Dundon, W.G.; Satin, B.; Molinari, M.; Tognon, G.; Grandi, G.; Del Giudice, G.; Rappuoli, R.; Montecucco, C. The Helicobacter pylori neutrophile-activating protein is an iron-binding protein with dodecameric structure. Mol. Microbiol. 1999, 34, 238–246. [Google Scholar] [CrossRef]
- Wiedenheft, B.; Mosolf, J.; Willits, D.; Yeager, M.; Dryden, K.A.; Young, M.; Douglas, T. An archaeal antioxidant: Characterization of a Dps-like protein from Sulfolobus solfataricus. Proc. Nat. Acad. Sci. USA 2005, 102, 10551–10556. [Google Scholar] [CrossRef]
- Ramsay, B.; Wiedenheft, B.; Allen, M.; Gauss, G.H.; Lawrence, C.M.; Young, M.; Douglas, T. Dps-like protein from the hyperthermophilic archaeon Pyrococcus furiosus. J. Inorg. Biochem. 2006, 100, 1061–1068. [Google Scholar] [CrossRef] [PubMed]
- Huergo, L.F.; Rahman, H.; Ibrahimovic, A.; Day, C.J.; Korolik, V. Campylobacter jejuni Dps protein binds DNA in the presence of iron or hydrogen peroxide. J. Bacteriol. 2013, 195, 1970–1978. [Google Scholar] [CrossRef] [PubMed]
- Xia, X.; Larios-Valencia, J.; Lin, Z.; Xiang, F.; Kan, B.; Wang, H.; Zhu, J. OxyR-activated expression of Dps is important for Vibrio cholerae oxidative stress resistance and pathogenesis. PLoS ONE 2017, 12, e0171201. [Google Scholar] [CrossRef] [PubMed]
- Ebrahimi, K.H.; Hagedoorn, P.L.; Hagen, W.R. Unity in the biochemistry of the iron-storage proteins ferritin and bacterioferritin. Chem. Rev. 2015, 115, 295–326. [Google Scholar] [CrossRef]
- Rivera, M. Bacterioferritin: Structure, dynamics, protein-protein interactions at play in iron storage and mobilization. Acc. Chem. Rev. 2017, 50, 331–340. [Google Scholar] [CrossRef]
- Lawson, D.M.; Artymiuk, P.J.; Yewdall, S.J.; Smith, J.M.; Livingstone, C.J.; Treffry, A.; Luzzago, A.; Levi, S.; Arosio, P.; Cesareni, G.; et al. Solving the structure of human H ferritin by genetically engineering intermolecular crystal contacts. Nature 1991, 349, 541–544. [Google Scholar] [CrossRef]
- Harrison, P.M.; Arosio, P. The ferritins: Molecular properties, iron storage function and cellular regulation. Biochim. Biophys. Acta-Bioenerg. 1996, 1275, 161–203. [Google Scholar] [CrossRef]
- Yokoyama, H.; Tsuruta, O.; Akao, N.; Fujii, S. Crystal structure of Helicobacter pylori neutrophil-activating protein with a di-nuclear ferroxidase center in a zinc or cadmium-bound form. Biochem. Biophys. Res. Commun. 2012, 422, 745–750. [Google Scholar] [CrossRef]
- Imlay, J.A. The molecular mechanisms and physiological consequences of oxidative stress: Lessons from a model bacterium. Nat. Rev. Microbiol. 2013, 11, 443–454. [Google Scholar] [CrossRef]
- Papinutto, E.; Dundon, W.G.; Pitulis, N.; Battistutta, R.; Montecucco, C.; Zanotti, G. Structure of two iron-binding proteins from Bacillus anthracis. J. Biol. Chem. 2002, 277, 15093–15098. [Google Scholar] [CrossRef]
- Zeth, K.; Sancho-Vaello, E.; Okuda, M. Metal positions and translocation pathways of the dodecameric ferritin-like protein Dps. Inorg. Chem. 2019, 58, 11351–11363. [Google Scholar] [CrossRef] [PubMed]
- Altuvia, S.; Almiron, M.; Huisman, G.; Kolter, R.; Storz, G. The dps promoter is activated by OxyR during growth and by IHF and s in stationary phase. Mol. Microbiol. 1994, 13, 265–272. [Google Scholar] [CrossRef] [PubMed]
- Lomovskaya, O.L.; Kidwell, J.P.; Matin, A. Characterization of the sigma 38-dependent expression of a core Escherichia coli starvation gene, pexB. J. Bacteriol. 1994, 176, 3928–3935. [Google Scholar] [CrossRef][Green Version]
- Azam, T.A.; Ishihama, A. Twelve species of the nucleoid associated protein from Escherichia coli. Sequence recognition specificity and DNA binding affinity. J. Biol. Chem. 1999, 274, 33105–33113. [Google Scholar] [CrossRef] [PubMed]
- Sato, Y.T.; Watanabe, S.; Kenmotsu, T.; Ichikawa, M.; Yoshikawa, Y.; Teramoto, J.; Imanaka, T.; Ishihama, A.; Yoshikawa, K. Structural change of DNA induced by nucleoid proteins: Growth phase-specific Fis and stationary phase-specific Dps. Biophys. J. 2013, 105, 1037–1044. [Google Scholar] [CrossRef] [PubMed]
- Grainger, D.C.; Goldberg, M.D.; Lee, D.J.; Busby, S.J.W. Selective repression by Fis and H-NS at the Escherichia coli dps promoter. Mol. Microbiol. 2008, 68, 1366–1377. [Google Scholar] [CrossRef] [PubMed]
- Sanchuki, H.B.S.; Valdameri, G.; Moure, V.R.; Oliveira, M.A.; Pedrosa, F.O.; Souza, E.M.; Korolik, V.; Huergo, L.F. Purification of the Campylobacter jejuni Dps protein assisted by its high melting temperature. Protein Exp. Purif. 2015, 111, 105–110. [Google Scholar] [CrossRef] [PubMed]
- Moparthi, V.K.; Li, X.; Vavitsas, K.; Dzhygyr, I.; Sandh, G.; Magnuson, A.; Stensjö, K. The two Dps proteins, NpDps2 and NpDps5, are involved in light-induced oxidative stress tolerance in the N2-fixing cyanobacterium Nostoc punctiforme. Biochim. Biophys. Acta 2016, 1857, 1766–1776. [Google Scholar] [CrossRef]
- Chen, H.; Xu, G.; Zhao, Y.; Tian, B.; Lu, H.; Yu, X.; Xu, Z.; Ying, N.; Hu, S.; Hua, Y. A novel OxyR sensor and regulator of hydrogen peroxide stress with one cysteine residue in Deinococcus radiodurans. PLoS ONE 2008, 3, e1602. [Google Scholar] [CrossRef]
- Santos, S.P.; Mitchell, E.P.; Franquelim, H.G.; Castanho, M.A.R.B.; Abreu, I.A.; Romão, C.V. Dps from Deinococcus radiodurans: Oligomeric forms of Dps1 with distinct cellular functions and Dps2 involved in metal storage. FEBS J. 2015, 282, 4307–4327. [Google Scholar] [CrossRef]
- Nguyen, K.H.; Grove, A. Metal binding at the Deinococcus radiodurans Dps-1 N-terminal metal site controls dodecameric assembly and DNA binding. Biochemistry 2012, 51, 6679–6689. [Google Scholar] [CrossRef] [PubMed]
- Reon, B.J.; Nguyen, K.H.; Bhattacharyya, G.; Grove, A. Functional comparison of Deinococcus radiodurans Dps proteins suggests distinct in vivo roles. Biochem. J. 2012, 447, 381–391. [Google Scholar] [CrossRef] [PubMed]
- Santos, S.P.; Cuypers, M.G.; Round, A.; Finet, S.; Narayanan, T.; Mitchell, E.P.; Romão, C.V. SAXS structural studies of Dps from Deinococcus radiodurans highlights the conformation of the mobile N-terminal extensions. J. Mol. Biol. 2017, 429, 667–687. [Google Scholar] [CrossRef] [PubMed]
- Santos, S.P.; Yang, Y.; Rosa, M.T.G.; Rodrigues, M.A.A.; De La Tour, C.B.; Sommer, S.; Teixeira, M.; Carrondo, M.A.; Cloetens, P.; Abreu, I.A.; et al. The interplay between Mn and Fe in Deinococcus radiodurans triggers cellular protection during paraquat-induced oxidative stress. Sci. Rep. 2019, 9, 17217. [Google Scholar] [CrossRef] [PubMed]
- Lee, C.; Choi, N.; Bae, M.K.; Choo, K.; Lee, S.-J. Transposition of insertion sequences was triggered by oxidative stress in radiation-resistant bacterium Deinococcus geothermalis. Microorganisms 2019, 7, 446. [Google Scholar] [CrossRef]
- Antipov, S.S.; Tutukina, M.N.; Preobrazhenskaya, E.V.; Kondrashov, F.A.; Patrushev, M.V.; Toshchakov, S.V.; Dominova, I.; Shvyreva, U.S.; Vrublevskaya, V.V.; Morenkov, O.S.; et al. The nucleoid protein Dps binds genomic DNA of Escherichia coli in a non-random manner. PLoS ONE 2017, 12, e0182800. [Google Scholar] [CrossRef]
- Ceci, P.; Cellai, S.; Falvo, E.; Rivetti, C.; Rossi, G.L.; Chiancone, E. DNA condensation and self-aggregation of Escherichia coli Dps are coupled phenomena related to the properties of the N-terminus. Nucleic Acid Res. 2004, 32, 5935–5944. [Google Scholar] [CrossRef]
- Grove, A.; Wilkinson, S.P. Differential DNA binding and protection by dimeric and dodecameric forms of the ferritin homolog Dps from Deinococcus radiodurans. J. Mol. Biol. 2005, 347, 495–508. [Google Scholar] [CrossRef]
- Romão, C.V.; Mitchell, E.P.; McSweeney, S. The crystal structure of Deinococcus radiodurans Dps protein (DR2263) reveals the presence of a novel metal centre in the N-terminus. J. Biol. Inorg. Chem. 2006, 11, 891–902. [Google Scholar]
- Magerand, R.; Rey, P.; Blanchard, L.; de Groot, A. Redox signaling through zinc activates the radiation response in Deinococcus bacteria. Sci. Rep. 2021, 11, 4528. [Google Scholar] [CrossRef]
- Ohba, H.; Satoh, K.; Yanagisawa, T.; Narumi, I. The radiation responsive promoter of the Deinococcus radiodurans pprA gene. Gene 2005, 363, 133–141. [Google Scholar] [PubMed]
- Misra, H.S.; Khairnar, N.P.; Kota, S.; Shrivastava, S.; Joshi, V.P.; Apte, S.K. An exonuclease I-sensitive DNA repair pathway in Deinococcus radiodurans: A major determinant of radiation resistance. Mol. Microbiol. 2006, 59, 1308–1316. [Google Scholar] [CrossRef] [PubMed]

Disclaimer/Publisher’s Note: The statements, opinions and data contained in all publications are solely those of the individual author(s) and contributor(s) and not of MDPI and/or the editor(s). MDPI and/or the editor(s) disclaim responsibility for any injury to people or property resulting from any ideas, methods, instructions or products referred to in the content. |
© 2022 by the authors. Licensee MDPI, Basel, Switzerland. This article is an open access article distributed under the terms and conditions of the Creative Commons Attribution (CC BY) license (https://creativecommons.org/licenses/by/4.0/).
Share and Cite
Bae, M.K.; Shin, E.; Lee, S.-J. Complementary Roles of Two DNA Protection Proteins from Deinococcus geothermalis. Int. J. Mol. Sci. 2023, 24, 469. https://doi.org/10.3390/ijms24010469
Bae MK, Shin E, Lee S-J. Complementary Roles of Two DNA Protection Proteins from Deinococcus geothermalis. International Journal of Molecular Sciences. 2023; 24(1):469. https://doi.org/10.3390/ijms24010469
Chicago/Turabian StyleBae, Min K., Eunjung Shin, and Sung-Jae Lee. 2023. "Complementary Roles of Two DNA Protection Proteins from Deinococcus geothermalis" International Journal of Molecular Sciences 24, no. 1: 469. https://doi.org/10.3390/ijms24010469
APA StyleBae, M. K., Shin, E., & Lee, S.-J. (2023). Complementary Roles of Two DNA Protection Proteins from Deinococcus geothermalis. International Journal of Molecular Sciences, 24(1), 469. https://doi.org/10.3390/ijms24010469

